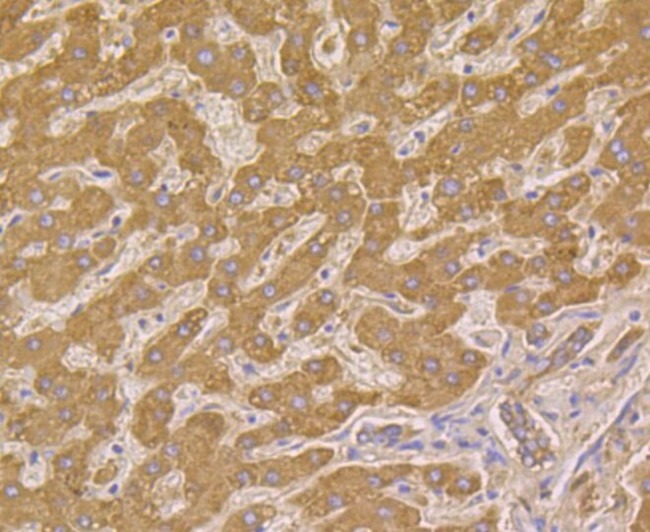
HSPE1 Antibody in Immunohistochemistry (Paraffin) (IHC (P))

Search
Invitrogen
HSPE1 Recombinant Rabbit Monoclonal Antibody (JG82-34)
{{$productOrderCtrl.translations['antibody.pdp.commerceCard.promotion.promotions']}}
{{$productOrderCtrl.translations['antibody.pdp.commerceCard.promotion.viewpromo']}}
{{$productOrderCtrl.translations['antibody.pdp.commerceCard.promotion.promocode']}}: {{promo.promoCode}} {{promo.promoTitle}} {{promo.promoDescription}}. {{$productOrderCtrl.translations['antibody.pdp.commerceCard.promotion.learnmore']}}








Please note: We are reviewing Western blot images included in the antibody testing data in our catalog, including those provided by third parties. Unless expressly labeled or annotated as “raw-unedited”, Western blot images included in the antibody testing data in our catalog may have been edited, optimized or otherwise adjusted for presentation.
产品信息
MA5-34778
种属反应
宿主/亚型
Expression System
分类
类型
克隆号
抗原
偶联物
形式
浓度
规格
纯化类型
保存液
内含物
保存条件
运输条件
RRID
产品详细信息
Positive Control: Mouse liver tissue, rat testis tissue, human liver cancer tissue, human colon tissue, mouse kidney tissue.
靶标信息
The heat shock proteins (HSPs) comprise a group of highly conserved, abundantly expressed proteins with diverse functions, including the assembly and sequestering of multiprotein complexes, transportation of nascent polypeptide chains across cellular membranes and regulation of protein folding. Heat shock proteins (also known as molecular chaperones) fall into six general families: HSP 90, HSP 70, HSP 60, the low molecular weight HSPs, the immunophilins and the HSP 110 family. The low molecular weight family includes HSP 10, HSP 20, HSP 27 (Heme Oxygenase 1), HSP 32 and HSP 40. Chaperonins are ubiquitous, indispensable proteins that facilitate protein folding in an ATP-dependent manner, enhancing the yield of properly folded substrate protein under conditions where spontaneous folding does not occur. Chaperonins are typified by the E. coli heat-shock proteins GroEL and GroES (HSP 10). HSP 10 is a heptameric ring of identical 10 kDa subunits that binds to each end of GroEL to form a symmetric, functional heterodimer.
仅用于科研。不用于诊断过程。未经明确授权不得转售。
篇参考文献 (0)
生物信息学
蛋白别名: 10 kDa chaperonin; 10 kDa heat shock protein, mitochondrial; 10kDa Chaperonin; CH10; Chaperonin 10; Cpn 10; CPN10; Early-pregnancy factor; EPF; Heat shock 10 kD protein 1 (chaperonin 10); heat shock 10 kDa protein 1 (chaperonin 10); Heat shock protein family E member 1; HSP; Hsp10; mitochondrial chaperonin 10
基因别名: 10kDa; Cpn10; Hsp10; HSPE1; mt-cpn10
UniProt ID: (Mouse) Q64433
Entrez Gene ID: (Rat) 25462, (Mouse) 15528